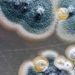
Jenis Jamur Berbahaya Ini Bisa Menyebar Lebih Luas Saat Cuaca Panas

Jakarta, KabarSDGs – Saat ini, banyak produk dengan label “probiotik” atau “prebiotik” terlihat di supermarket maupun apotek. Dari yogurt, minuman dalam kemasan, hingga suplemen, semuanya mengklaim dapat meningkatkan kesehatan pencernaan. Namun, sebenarnya apa yang membedakan probiotik dan prebiotik?
Secara sederhana, probiotik adalah organisme hidup, seperti bakteri dan ragi, yang memberikan manfaat bagi kesehatan jika dikonsumsi dalam jumlah yang tepat. Umumnya, probiotik bisa ditemukan dalam makanan fermentasi seperti yogurt, kimchi, tempe, dan kombucha.
Di sisi lain, prebiotik berfungsi sebagai “makanan” bagi probiotik. Prebiotik terdiri dari serat khusus—seperti inulin, pektin, dan resistant starch—yang tidak dapat dicerna oleh tubuh, tetapi sangat penting sebagai pasokan bagi bakteri baik yang berada di dalam usus.
Jika kamu penasaran tentang kaitan informasi ini dengan microbiome, berikut penjelasannya. Microbiome adalah kumpulan mikroorganisme yang berada di dalam tubuh kita—di area mulut, kulit, sistem pernapasan, sistem genitourinari, dan terutama di dalam usus. Setiap individu memiliki microbiome yang berbeda dan dapat berubah-ubah bergantung pada kebiasaan hidup, pola makan, stres, penggunaan antibiotik, serta tingkat kebersihan.
Ketika keseimbangan antara bakteri baik dan jahat dalam tubuh terganggu atau jumlah jenis mikroorganisme yang ada terlalu sedikit, hal ini bisa menyebabkan microbiome menjadi ‘tidak sehat’. Ini dikenal sebagai dysbiosis, yang dapat memicu berbagai masalah seperti diare, sembelit, irritable bowel syndrome (IBS), gusi berdarah, eksim, bahkan jerawat. Oleh karena itu, baik probiotik dan prebiotik sering dipromosikan sebagai cara untuk mempertahankan kesehatan dan keragaman microbiome.
Namun, sayangnya, berdasarkan beberapa penelitian, ternyata suplemen probiotik belum terbukti efektif dalam memperbaiki keragaman microbiome, bahkan ketika dikonsumsi bersamaan dengan antibiotik. Salah satu penelitian menunjukkan bahwa suplemen probiotik dapat memperlambat pemulihan microbiome setelah penggunaan antibiotik.
Penelitian mengenai prebiotik juga masih terbatas. Namun, ada beberapa studi yang mencoba menggabungkan konsumsi prebiotik dan probiotik (disebut sinbiotik) untuk mengamati dampaknya terhadap kondisi tertentu seperti demensia, Parkinson, dan diabetes. Sayangnya, hasilnya belum menunjukkan kejelasan dan tidak cukup kuat untuk digunakan sebagai rekomendasi rutin.
Tetapi tidak perlu khawatir, kamu masih bisa menjaga kesehatan usus tanpa harus membeli suplemen mahal. Caranya? Konsumsi makanan yang secara alami mengandung probiotik dan prebiotik. Probiotik bisa kamu peroleh dari makanan fermentasi seperti yogurt, keju, miso, tempe, dan kimchi. Sementara itu, prebiotik bisa ditemukan dalam semua makanan kaya serat, artinya semua makanan berbasis nabati: sayuran, buah-buahan, kacang-kacangan, dan biji-bijian.
Dr. Evangeline Mantzioris menyatakan, “Kunci untuk menjaga microbiome yang sehat adalah variasi makanan nabati dalam dietmu. Ini esensial untuk memberi makan semua jenis bakteri baik yang berada di dalam usus kita.”
Alih-alih mengandalkan suplemen, lebih baik fokus pada peningkatan konsumsi makanan utuh yang juga kaya akan nutrisi penting bagi tubuh. Pedoman pola makan sehat dari pemerintah Australia juga merekomendasikan untuk banyak mengonsumsi makanan nabati dan fermentasi seperti yogurt dan keju. Kombinasi ini adalah pilihan terbaik untuk menjaga kesehatan microbiome kamu.

Discussion about this post